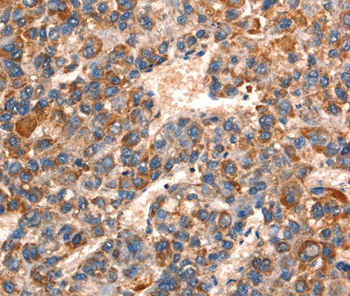
Anti-GJA8 Antibody

Goat anti-Connexin 50 / GJA8 Antibody
EB09672
ApplicationsELISA
Product group Antibodies
ReactivityBovine, Canine, Human, Mouse, Rat
TargetGJA8
Overview
- SupplierEverest Biotech
- Product NameGoat anti-Connexin 50 / GJA8 Antibody
- Delivery Days Customer5
- ApplicationsELISA
- Applications SupplierPep-ELISA
- CertificationResearch Use Only
- ClonalityPolyclonal
- Concentration0.5 mg/ml
- Gene ID2703
- Target nameGJA8
- Target descriptiongap junction protein alpha 8
- Target synonymsCAE, CAE1, CTRCT1, CX50, CZP1, MP70, gap junction alpha-8 protein, cell surface glycoprotein, connexin 50, gap junction alpha 8, gap junction membrane channel protein alpha-8, gap junction protein alpha 8 50kDa, lens fiber protein MP70, lens intrinsic membrane protein MP70
- HostGoat
- Scientific DescriptionRefSeq number(s): NP_005258.2. GeneIDs all Nonhuman: 14616 (mouse); 29601 (rat);. Purification: Antigen affinity purified. Names and symbols: GJA8; gap junction protein, alpha 8, 50kDa; CAE; CAE1; CX50; CZP1; MP70; OTTHUMP00000025757; connexin 50; connexin-50; gap junction alpha-8 protein; gap junction membrane channel protein alpha-8; lens fiber protein MP70; lens intrinsic membrane protein MP
- ReactivityBovine, Canine, Human, Mouse, Rat
- Reactivity SupplierHuman, Mouse, Rat, Dog, Cow
- Storage Instruction-20°C
- UNSPSC12352203